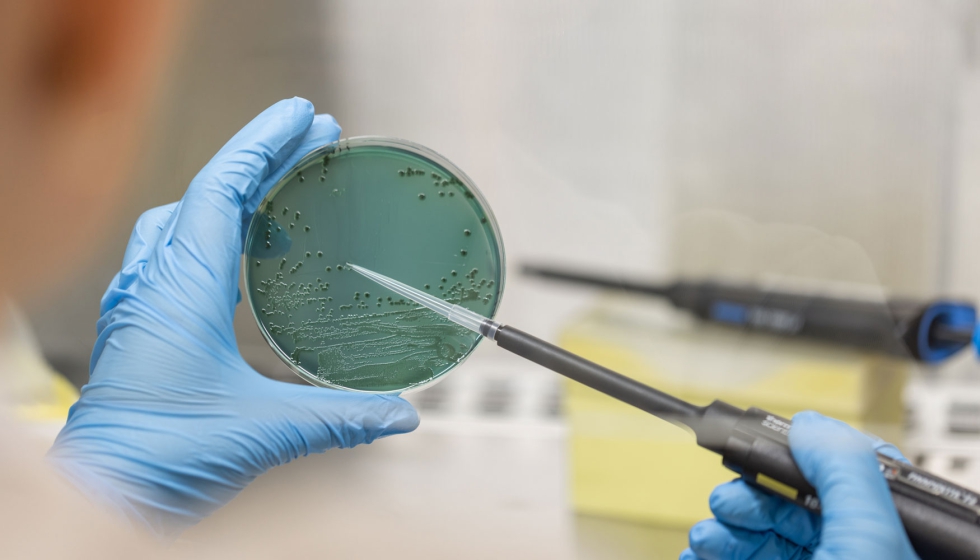
Elaborar zumos sin higienizar el equipo puede propagar bacterias peligrosas

Identifican los puntos críticos de contaminación en la elaboración de zumos sin pasteuritzar
Un equipo de investigadoras de Agrotecnio y la Universidad de Lleida ha publicado un estudio pionero que analiza cómo ciertos patógenos pueden contaminar zumos sin pasteurizar elaborados con frutas y hortalizas, a través de superficies de manipulación contaminadas.
La investigación ha demostrado que tres bacterias de elevado riesgo para la salud Salmonella enterica, Escherichia coli O157:H7 y Listeria monocytogenes pueden transferirse desde guantes, cuchillos y tablas de cortar hacia las frutas y hortalizas y, posteriormente, al zumo final obtenido.
El estudio se ha centrado en las etapas de producción de zumos frescos de fresa, manzana y remolacha, reproduciendo situaciones habituales en entornos domésticos o pequeños obradores, como la elaboración consecutiva de varios lotes con el mismo equipo sin limpiarlo adecuadamente.
Los resultados evidencian un riesgo real de contaminación cruzada: tras un primer lote de zumo elaborado con productos contaminados, las bacterias pueden persistir en los lotes posteriores de zumo, aun utilizando fruta no contaminada.

En cuanto al uso de superficies, las tablas de cortar y los guantes contaminados son los que promueven una transferencia bacteriana más elevada, mientras que los cuchillos representan un riesgo más bajo.
Respecto a la materia prima, la supervivencia de los patógenos en el zumo varía según la fruta u hortaliza. El zumo de fresa reduce más rápidamente la presencia bacteriana, mientras que el zumo de remolacha permite una supervivencia más prolongada, probablemente por el efecto de su pH más alto y de algunos compuestos naturales presentes en esta hortaliza. El zumo de manzana muestra un comportamiento intermedio.
Este trabajo nos da información muy valiosa para la industria, pero también para productores locales y consumidores que elaboran zumos frescos. Demostramos que, en ausencia de tratamientos térmicos como la pasteurización, se necesitan protocolos de higiene muy estrictos para minimizar riesgos, especialmente en procesos donde se mezclan frutas y verduras, explica Isma Neggazi, investigadora de Agrotecnio y la Universidad de Lleida.
Las investigadoras recomiendan explorar tecnologías alternativas para garantizar la seguridad de estos productos, como la aplicación de alta presión o el uso de compuestos antimicrobianos naturales. Además, insisten en que el control de la contaminación en las primeras fases del procesamiento es clave para proteger la salud de los consumidores.
El estudio forma parte del proyecto QUALISAFEJUICE, financiado por el Ministerio de Ciencia e Innovación, que busca mejorar la calidad y seguridad microbiológica de los zumos frescos. Este trabajo del grupo de Biología y Tecnología Postcosecha de Agrotecnio - Universidad de Lleida, es uno de los primeros en analizar de forma sistemática la transferencia de patógenos durante la elaboración de zumos en condiciones reales de manipulación. La investigación ha sido liderada por Isma Neggazi, Pilar Colás-Modá, Immaculada Viñas e Isabel Alegre.



